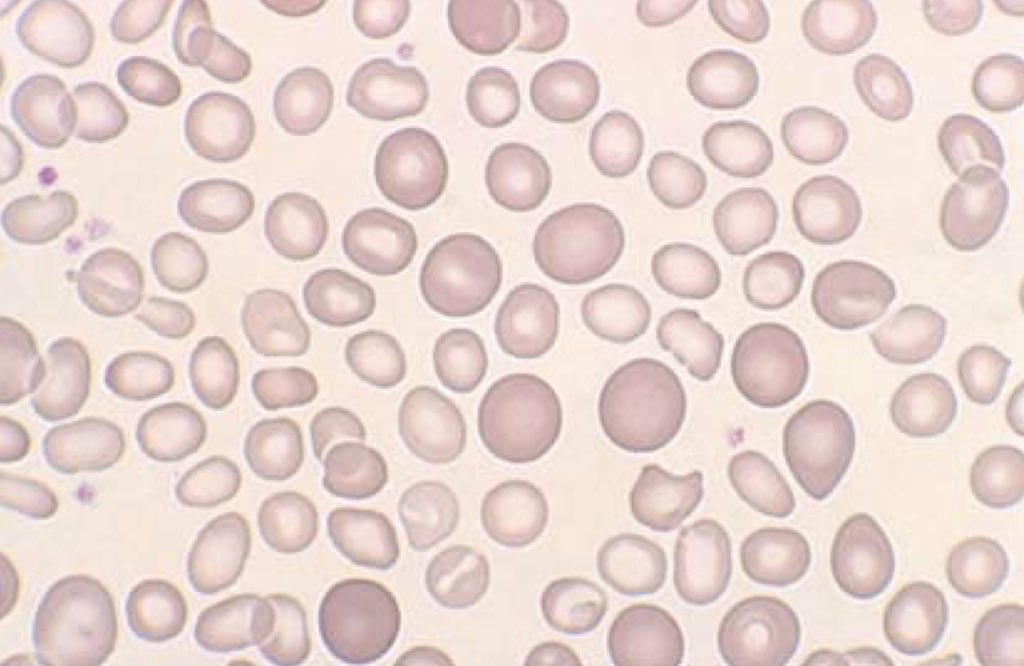

يلا بسم الله مع ثريد أنيميا نقص الحديد، بيكون طويل شوي بس أبيه يكون شامل ??
أول شي شنو يعني أنيميا نقص الحديد؟ هي حالة يكون فيها دمك أقل من المستوى الطبيعي، والحديد كذلك ، الحديد مهم جِداً في الجسم لأنه يكون لنا بروتين إسمه hemoglobin
شنو وظيفة هذا البروتين؟ هو البروتين الغالب اللي داخل الكريات الدم الحمراء يساعد في نقل الإكسجين من وإلى الأنسجه ، المعدل الطبيعي له بالنسبه للرجال 14-18g ، أما بالنسبة للنساء 12-16g .
طبعاً أنيميا نقص الحديد موجودة في النساء بشكل أكبر والسبب يعود للدورة الشهرية والحمل ، ولما يكون عندك نقص في الحديد ف جسمك ماراح ياخذ كفايته من الإكسجين لأنه تصنيع الهيموغلوبين راح يقل
المعدل الطبيعي للحديد في الجسم هو من 4-5g ، أكثر من نصه راح يُستخدم في تصنيع الهيموغلوبين ، ومن 15-30% راح يخُزن لحين الحاجه له في نخاع العظم والكبد
طيب شنو الاسباب؟ عدم أخذ الكمية الكافيه للحديد ، فقدان الدم بشكل كبير ، وفي بعض الحالات يكون فيه مشكلة في الجسم في إمتصاص الحديد ، زيادة الحاجه للحديد مثل المرأه الحامل
أهم الأعراض تتلخص في : تعب ، لون الجلد شاحب ومايل للأزرق ، نبضات القلب غير منتظمة، ألم في الصدر، برودة اليد، تشققات في الفم، الرغبه في أكل أشياء غريبه مثل الثلج أو الطين ،spoon- shaped finger nails
طيب قبل ما أبتدي شرح التشخيص لازم نراجع كم شيء
MCV هو متوسط حجم الخليه والمعدل الطبيعي يكون من 80-95 ، لو كان أكثر نقول microcytic ، لو كان نورمال نقول normocytic ، لو كان أقل نقول microcytic ولو أقل hypochromic ولو أكثر hyperchromic
MCHC هو تركيز الهيموغلوبين في حجم معين من الدم والمعدل الطبيعي له من 32-36g
طيب شنو الإختبارات اللي بسويها في اللاب عشان أعرف هالشخص معه أنيميا نقص الحديد أو لا ؟ طبعاً أول شيء بسوي مسحة للدم وبشوف فيها الأشياء اللي ذكرتها مُسبقاً
بعدها بسوي CBC اللي هو تعداد كامل للدم وراح أشوف MCV,MCH,MCHC كلهم أقل من المعدل الطبيعي وكذلك RBCs ( خلايا الدم الحمراء ) وأيضاً WBCs ( خلايا الدم البيضاء ) ، لكن الصفائح راح تكون مرتفعه
طيب فيه إختبارات تأكيدية عشان أتاكد مليون بالميه إن هالشخص معه أنيميا نقص الحديد اللي هي serum iron,transferrin saturation, ferritin هالإختبارات كلهم راح يكونون low ، وعندنا إختبار TIBC الوحيد بيكون مرتفع عندنا
صح فيه نقطة نسيتها اللي هي مصادر الحديد، كثيرة ومن ضمنها اللحوم الحمراء، الأوراق الخضراء،بيض،فاصولياء
طيب بالنسبة للعلاج يعتمد على حسب الحالة وشدتها، ويتضمن تغير نظام الأكل ، حبوب الحديد وفي الحالات اللي محتاجين حديد بشكل مُستعجل راح ننقل له دم ( فيه خلايا دم حمراء فقط )
خلاص خلصت الثريد وسوري على الإطالة، أي سؤال أنا بالخدمة ❤️❤️
عُذراً فيه شيء غلط، بس بعدلهم MCV متوسط حجم الخليه والمعدل الطبيعي يكون من 80-95 اذا أكثر نقول macrocytic اذا اقل microcytic واذا نورمال normocytic
MCH هو متوسط كمية الهيموغلوبين داخل الكُرية والمعدل الطبيعي هو من 27-33 لو كان نورمال normochromic لو كان أكثر hyperchromic لو كان أقل hypochromic ?
جاري تحميل الاقتراحات...